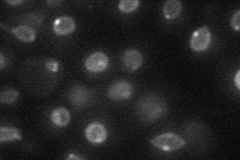
YLR457C

View description
Spindle pole body (SPB) component, required for the insertion of the duplication plaque into the nuclear membrane during SPB duplication; essential for bipolar spindle formation; component of the Mps2p-Bbp1p complex
Localization:
Intensity:
Fold change:
Significance:
-
C’ GFP library in SD

below threshold16.65 -
N' NOP1pr-GFP in SD

punctate,nuclear periphery33.8725 -
N' TEF2pr-mCherry in SD
punctate,nuclear periphery17.8412 -
N' NATIVEpr-GFP in SD

below threshold23.9703 -
N' TEF2pr-VC and Cyto-VN in SD

#N/A0 -
C’ GFP library in SD+DTT

cytosol17.961.07No -
C’ GFP library in SD+H2O2

cytosol16.861.01No -
C’ GFP library in Starvation Media

cytosol17.251.03No -
C’ GFP library on the background of Pup2-DaMP

N/A -
C’ GFP library on the background of CCT mutant

N/A0N/AYes
